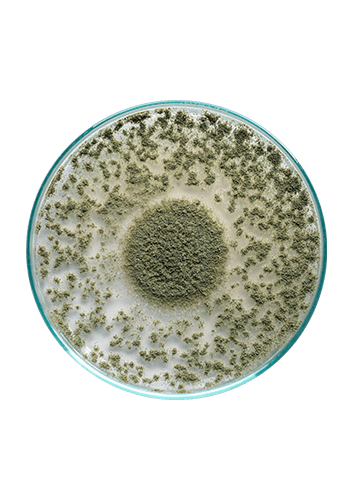
DigeZyme®

DigestEase with Tolerase®G
BENEFITS
- Digestive Enzymes to breakdown fat, protein, carbohydrates, plant fibre, gluten and dairy.
- For those who experience gas, bloating and stomach acidity.
- Ideal for supporting the absorption of nutrients from food.
60 doses
Couldn't load pickup availability
-
This product contains:
DigeZyme®
Digestive enzymes that break down a number of food groups and play a positive role in digestive disorders.

Tolerase® G
Research show that Tolerase® G supports healthy gluten digestion.

Product information
DigestEase contains Tolerase® G, which is sourced from the natural fungus Aspergillus niger. It's been scientifically shown to help digest gluten. It also contains the ingredient DigeZyme® which is made up five more essential digestive enzymes, which support the breakdown of our major food groups.
Adults:
Take 1 capsule before main meals.
Full Ingredients
Each vege capsule contains:
|
Ingredients |
Strength |
Units |
|---|---|---|
|
Tolerase® G |
115 |
mg |
|
DigeZyme® containing: |
50 |
mg |
|
Alpha amylase |
1200 |
DU |
|
Acid protease |
500 |
HUT |
|
Lactase |
200 |
LAC |
|
Cellulase |
55 |
CUT |
|
Lipase |
10 |
FIP |
Tolerase® G is a trademark of DSM. DigeZyme® is a trademark of Sabinsa.
Also contains: Magnesium stearate, calcium hydrogen phosphate, precipitated amorphous silica.
No added: Sugar, artificial colours, sweeteners, flavours or preservatives.
Suitable for vegans.
Consult your healthcare practitioner before taking this product if you are pregnant or breastfeeding.
You might also like
View all products-
5-HTP Mood Care
Stress, Sleep & Mood -
Antibiotic Support Probiotics
Specific Health Support -
B Complex Active
Stress, Sleep & Mood -
B12 Active Chews
Stress, Sleep & Mood -
Bladder Confidence
Specific Health Support -
Bladder Support
Women's Health






